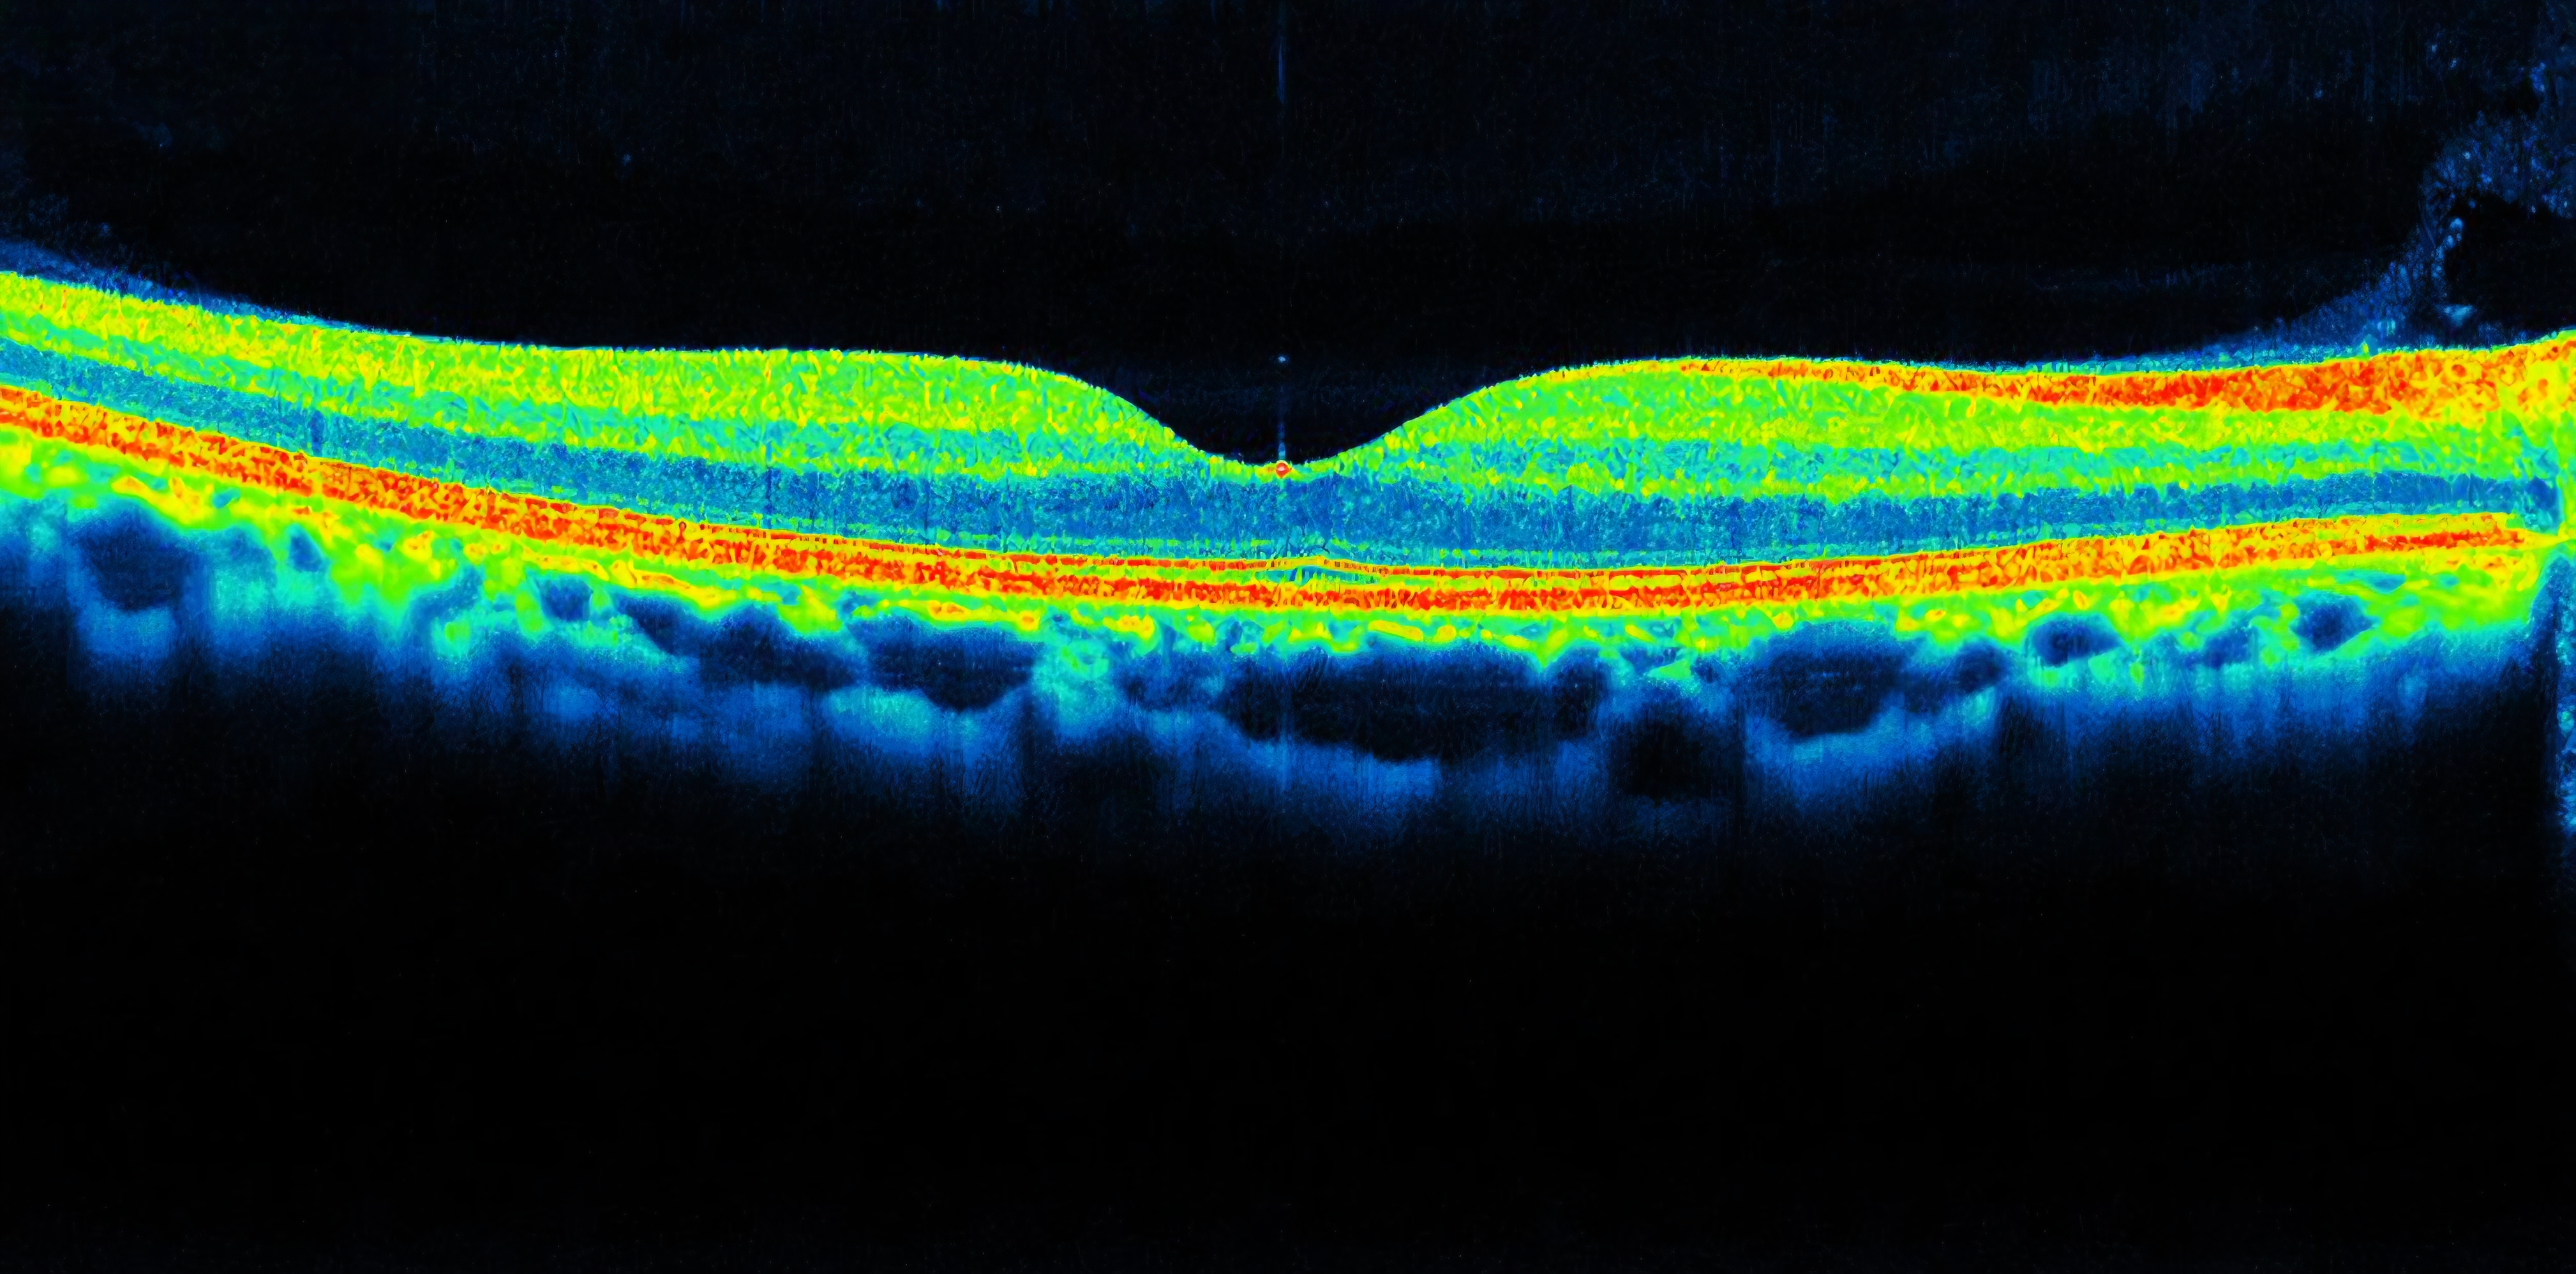

OCT Scanning
At R. A. Glass, we are passionate about eye health. As part of our commitment to provide you with the very highest standard of eye care, we have invested in cutting-edge Optical Coherence Tomography (OCT) technology which allows us to examine the back of your eyes in exceptional detail.